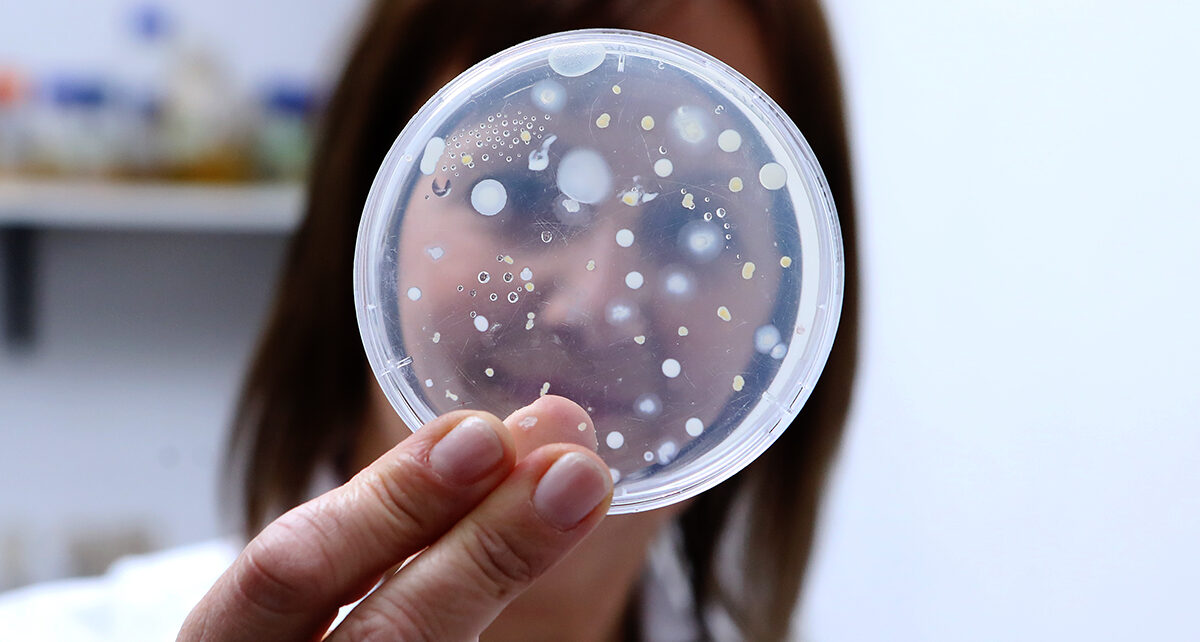

El Hotel Days Inn de Zárate fue escenario de «Prevencia Bonaerense 2025», el encuentro anual organizado por el Colegio de Profesionales de Higiene y Seguridad en el Trabajo de la Provincia de Buenos Aires, exclusivo para sus matriculados y con la presencia de referentes nacionales e internacionales de la prevención, la gestión de riesgos y […]
Etiqueta: portada
La Facultad de Odontología de la UNLP advirtió sobre estafas digitales y avanzan con acciones legales
La Facultad de Odontología de la Universidad Nacional de La Plata informó que se detectó “la circulación de mensajes fraudulentos mediante los cuales una persona ajena a la institución se hace pasar por personal administrativo para ofrecer turnos odontológicos y solicitar pagos indebidos”. Así, en un comunicado institucional, se recordó que la FOLP-UNLP “no solicita […]
Edelap realizó este año más de 3.500 actas de comprobación por conexiones eléctricas fraudulentas
Edelap intensificó las acciones contra el fraude eléctrico, labrando más de 3.500 actas de comprobación en 2025 por manipulación de medidores y conexiones clandestinas directas a la red. Esta cifra duplica las detecciones de 2024, ello como resultado de la incorporación de nuevos recursos tecnológicos y operativos para detectar y normalizar irregularidades. Del total, más […]
UNLP: Los microorganismos como estrategia ante la contaminación por hidrocarburos
Investigadoras de la Universidad Nacional de Plata, pertenecientes al Centro de Investigación y Desarrollo en Fermentaciones Industriales (CINDEFI, Facultad de Ciencias Exactas-UNLP-CONICET) desarrollan una tecnología basada en inoculantes microbianos para degradar hidrocarburos contaminantes provenientes de la industria petrolífera en la región de Vaca Muerta, Neuquén. Se trata de un bioinsumo elaborado a partir de bacterias nativas […]
Mega inversión de Camuzzi para exportar gas desde el Puerto La Plata
“LNG DEL PLATA”es el nuevo desarrollo energético de Camuzzi Gas Inversora S.A., la compañía controlante de las distribuidoras Camuzzi Gas Pampeana y Camuzzi Gas del Sur, destinado a la exportación del gas natural producido en Vaca Muerta a través de un barco de licuefacción (Floating LNG) ubicado en el Puerto La Plata, Provincia de Buenos […]
Sociedad Platense de Anestesiología: balance de 2025 y proyectos de calidad centrados en el paciente
La Sociedad Platense de Anestesiología (SPA) culmina el año 2025 reafirmando su compromiso con la seguridad del paciente y la innovación en la atención sanitaria. El Dr. Juan Manuel Boullosa, presidente de la SPA, dialogó con Comunidad Profesional radio y destacó los principales logros del período y los ambiciosos planes para el próximo año. Uno […]
«Las vacunas y el agua potable, los avances más importantes en la salud pública»
El Dr. Julio Dunogent, presidente del Colegio de Médicos Distrito 5 y secretario general del colegio de médicos de la provincia de Buenos Aires, dialogó con Comunidad Profesional radio (FM Classique 106.5, los viernes desde las 14) y abordó dos preocupaciones centrales de salud pública: la baja en la vacunación y el aumento significativo de […]
Puerto La Plata participó de ronda de negocios con eje en energía
El equipo del área comercial del Puerto La Plata, integrado por Rosana Raimondi y Alejandro Barone, participaron de la Ronda de Negocios Nacional e Internacional, que se llevó a cabo en el Teatro Argentino de La Plata. El encuentro, organizado Ministerio de Producción, Ciencia y Tecnología de la Provincia, contó con más de 40 empresas […]
Juraron los flamantes profesionales de Ciencias Informáticas
El Consejo Profesional de Ciencias Informáticas de la Provincia de Buenos Aires (CPCIBA) llevó adelante un nuevo acto de jura de profesionales e idóneos, realizado en su sede de calle 10 y 37, en La Plata. La ceremonia estuvo encabezada por el presidente de la entidad profesional, Pablo Barbosa, junto con integrantes de la Consejo […]
Nuevas matriculadas en el Colegio Profesional de Terapia Ocupacional
El Colegio Profesional de Terapia Ocupacional de la Provincia de Buenos Aires (COTOBA) celebró un nuevo acto de entrega de matrículas, realizado en la Asociación de Sordomudos de La Plata. El encuentro reunió a las flamantes matriculadas junto a familiares, colegas y autoridades del Colegio, en un ambiente de reconocimiento y crecimiento institucional. La ceremonia […]